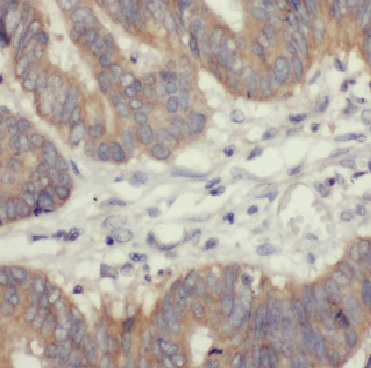
产品细节图片1

相关产品推荐更多 >
万千商家帮你免费找货
0 人在求购买到急需产品
- 详细信息
- 文献和实验
- 技术资料
- 免疫原:
protein phosphatase 1, regulatory(inhibitor) subunit 1B
- 亚型:
IgG
- 形态:
liquid
- 保存条件:
-20℃ 12月
- 克隆性:
polyclonal
- 标记物:
未标记
- 适应物种:
Human, Mouse, Rat
- 保质期:
-20℃ 12月
- 抗原来源:
protein phosphatase 1, regulatory(inhibitor) subunit 1B
- 目录编号:
FNab02244
- 级别:
科研
- 库存:
100
- 供应商:
武汉菲恩生物科技有限公司
- 宿主:
Rabbit
- 应用范围:
ELISA, IHC, WB
- 靶点:
PPP1R1B
- 抗体英文名:
PPP1R1B antibody
- 抗体名:
PPP1R1B抗体
- 规格:
50ug/100ug
| 规格: | 50ug | 产品价格: | ¥1050.0 |
|---|---|---|---|
| 规格: | 100ug | 产品价格: | ¥1750.0 |

产品介绍
| 产品名称 | PPP1R1B antibody |
| 中文名称 | PPP1R1B抗体 |
| 货号 | FNab02244 |
| 规格 | 50ug/100ug |
| 宿主 | Rabbit |
| 反应种属 | Human, Mouse, Rat |
| 验证应用 | ELISA, IHC, WB |
| 状态 | liquid |
| 纯化方法 | Immunogen affinity purified |
| 纯度 | ≥95% as determined by SDS-PAGE |
| 克隆性 | polyclonal |
| 亚型 | IgG |
| 免疫原 | protein phosphatase 1, regulatory(inhibitor) subunit 1B |
| 免疫原别称 | Protein phosphatase 1 regulatory subunit 1B|DARPP-32|Dopamine- and cAMP-regulated neuronal phosphoprotein|PPP1R1B|DARPP32 |
| Uniprot ID | Q9UD71 |
| 分子量 | 32 kDa |
| 建议稀释比例 | WB: 1:500-1:2000; IHC: 1:20-1:200 |
| 验证图片 | Immunohistochemistry of paraffin-embedded human colon cancer using FNab02244(DARPP32 antibody) at dilution of 1:100  mouse brain tissue were subjected to SDS PAGE followed by western blot with FNab02244(DARPP32 Antibody) at dilution of 1:1000 |
| 存储 | PBS with 0.02% sodium azide and 50% glycerol pH 7.3, -20℃ for 12 months(Avoid repeated freeze / thaw cycles.) |
| 注意事项 | PPP1R1B antibody仅供科研使用 |
菲恩生物抗体产品优势
种类齐全:有10000多种经过验证的免多抗和小鼠单抗,包括流式抗体、内参抗体、标签抗体、小分子化合物抗体、对照抗体等;
多种标记/非标记二抗:针对兔、羊、小鼠、大鼠、人等多个种属。100多种标记二抗,标记物包括HRP、Biotin、FITC、Cy3、Alexa Fluor 488、Alexa Fluor 594等,通过了蛋白质印迹、免疫荧光、免疫组织化学、流式细胞术和ELISA等免疫学相关应用的充分验证,可满足各种实验需求;
验证过多种实验:ELISA、WB、IHC、IF、IP、FC等应用,并进行了广泛的物种交叉实验。
风险提示:丁香通仅作为第三方平台,为商家信息发布提供平台空间。用户咨询产品时请注意保护个人信息及财产安全,合理判断,谨慎选购商品,商家和用户对交易行为负责。对于医疗器械类产品,请先查证核实企业经营资质和医疗器械产品注册证情况。
 文献和实验
文献和实验在免疫反应方面,基于抗原的刺激在体内形成、并与抗原作特异性结合的蛋白质之总称。其化学实质是免疫球蛋白。抗体,按照抗原抗体反应的类型可分别称为沉淀素、凝集素、溶血素、溶菌素、抗毒素、中和抗体等,但这些并不等于有相应的不同抗体存在,一般多只表明抗体反应的多样性而已。抗体在血清中含量最多(体液抗体=humoral antibody);含有某特定抗体的血清称为抗血或免疫血清。
机体在抗原物质刺激下,由B细胞分化成的浆细胞所产生的、可与相应抗原发生特异性结合反应的免疫球蛋白。因为最初有人用电泳证明血清中抗体活性在γ球蛋白部分,故曾把抗体统称为两种(γ)球蛋白。后来证明,抗体并不都在γ区;而且位于γ区的球蛋白,也不一定都具有抗体活性。1964年,世界卫生组织举行专门会议,将具有抗体活性以及与抗体相关的球蛋白统称为免疫球蛋白(Ig)。如骨髓瘤蛋白,巨球蛋白血症、冷球蛋白血症等患者血清中存在的异常免疫球蛋白以及“正常人”天然存在的免疫
指仅对一种抗原决定基的纯粹的抗体。这类抗体不可能通过将抗原 胞的 Hybridoma,在试管内制成了纯粹的单克隆抗体。用某种抗原使动物产生免疫感应,对应于抗原之不同部分可制成各种不同的抗体复合体。然而,因为一个产生抗体的细胞,只能产生一种抗体,所以骨髓肿瘤细胞与产生抗体细胞间的细胞杂种,可形成边产生抗体边增殖的 hybridoma,将每个杂种细胞进行克隆(无性繁殖系)培养,则一个克隆的细胞群只由单种类产生同一抗体的细胞所组成,这样得到的就是单克隆抗体。此抗体在测定
 技术资料
技术资料暂无技术资料 索取技术资料






